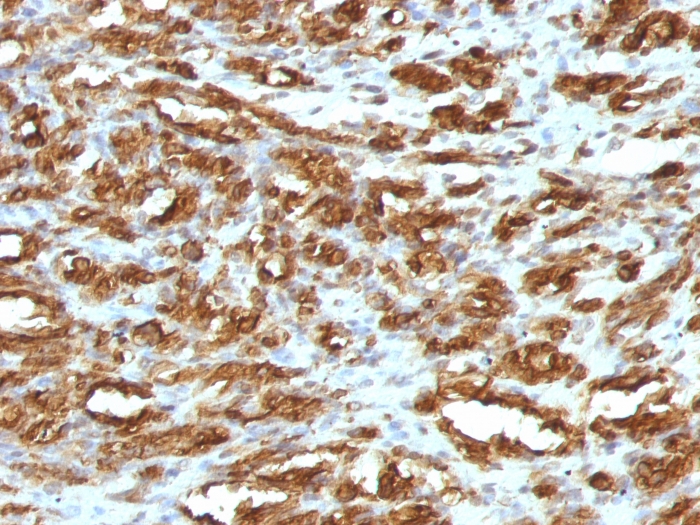

Formalin-fixed, paraffin-embedded human Leiomyosarcoma stained with Muscle Specific Actin Mouse Monoclonal Antibody (HHF35).
Formalin-fixed, paraffin-embedded human Rhabdomyosarcoma stained with Muscle Specific Actin Mouse Monoclonal Antibody (HHF35).

SDS-PAGE Analysis Purified Muscle Specific Actin Mouse Monoclonal Antibody (HHF35). Confirmation of Purity and Integrity of Antibody.
This antibody recognizes actin of skeletal, cardiac, and smooth muscle cells. It is not reactive with other mesenchymal cells except for myoepithelium. Actin can be resolved on the basis of its isoelectric points into three distinctive components: alpha, beta, and gamma in order of increasing isoelectric point. Anti-muscle specific actin recognizes alpha and gamma isotypes of all muscle groups. Non-muscle cells such as vascular endothelial cells and connective tissues are non-reactive. Also, neoplastic cells of non-muscle-derived tissue such as carcinomas, melanomas, and lymphomas are negative.It stains tumors of smooth muscle (leiomyomas and leiomyosarcomas) as well as skeletal muscle (rhabdomyomas and rhabdomyosarcomas).
There are no reviews yet.